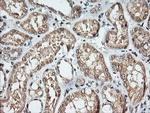
KLK8 Antibody in Immunohistochemistry (Paraffin) (IHC (P))

Search
OriGene
KLK8 Monoclonal Antibody (OTI10D3), TrueMAB™
{{$productOrderCtrl.translations['antibody.pdp.commerceCard.promotion.promotions']}}
{{$productOrderCtrl.translations['antibody.pdp.commerceCard.promotion.viewpromo']}}
{{$productOrderCtrl.translations['antibody.pdp.commerceCard.promotion.promocode']}}: {{promo.promoCode}} {{promo.promoTitle}} {{promo.promoDescription}}. {{$productOrderCtrl.translations['antibody.pdp.commerceCard.promotion.learnmore']}}
产品信息
TA506135
种属反应
宿主/亚型
分类
类型
克隆号
抗原
偶联物
形式
浓度
规格
纯化类型
保存液
内含物
保存条件
运输条件
靶标信息
Kallikreins are a subgroup of serine proteases having diverse physiological functions. Growing evidence suggests that many kallikreins are implicated in carcinogenesis and some have potential as novel cancer and other disease biomarkers. This gene is one of the fifteen kallikrein subfamily members located in tandem in a gene cluster on chromosome 19. The encoded protein may be involved in proteolytic cascade in the skin and may serve as a biomarker for ovarian cancer. Alternate splicing of this gene results in multiple transcript variants encoding different isoforms.
仅用于科研。不用于诊断过程。未经明确授权不得转售。
篇参考文献 (0)
生物信息学
蛋白别名: H NRPN; hK8; Kallikrein-8; kallikrein-8 isoform 14; kallikrein-related peptidase 8; Kallikrein8; Neuropsin; NP; Ovasin; PRO322; Serine protease 19; Serine protease TADG-14; Tumor-associated differentially expressed gene 14 protein; UNQ283
基因别名: HNP; KLK8; NP; NRPN; PRSS19; TADG14; UNQ283/PRO322
UniProt ID: (Human) O60259
Entrez Gene ID: (Human) 11202